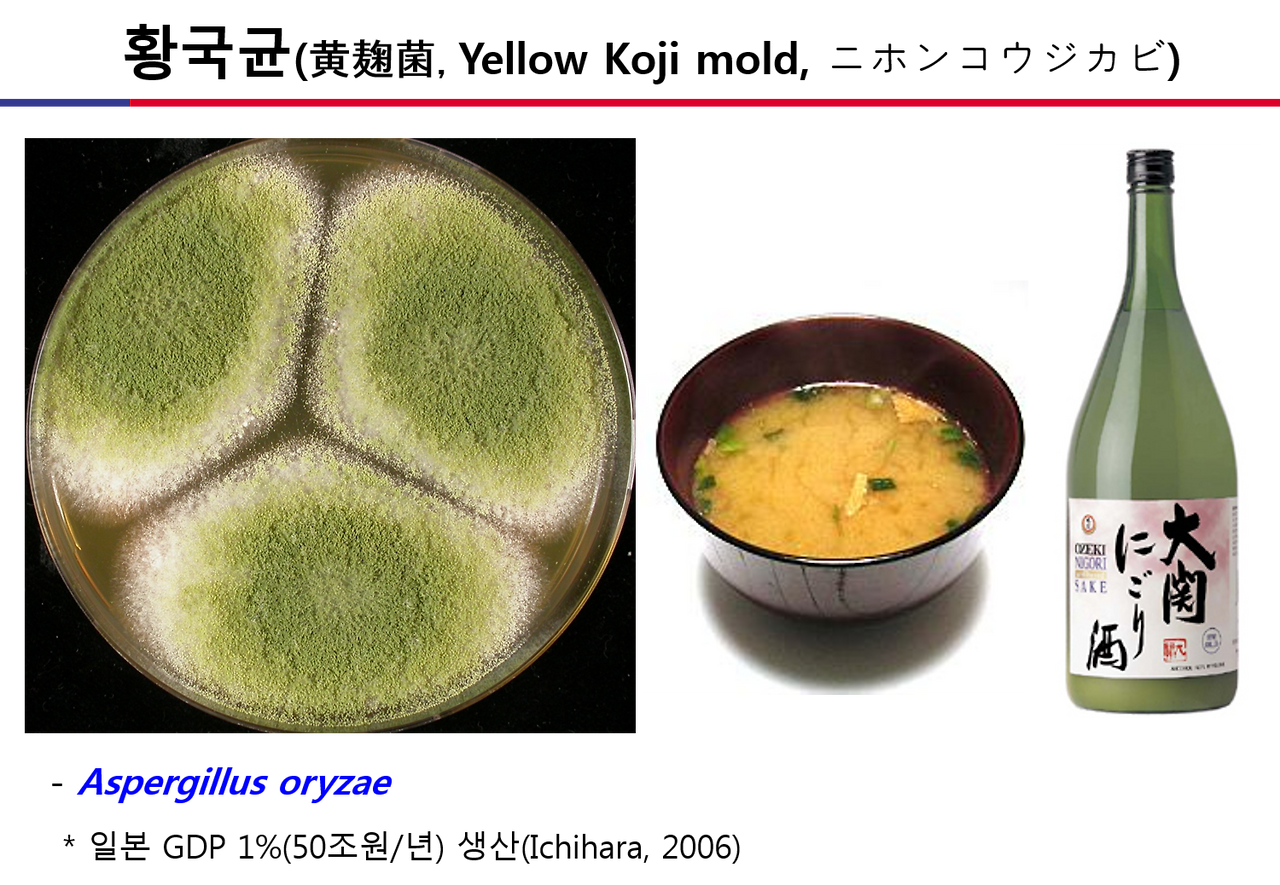
황국균.png

국균(누룩곰팡이)을 소개합니다.
곰팡이 이야기 17
지난 금요일 한국생명공학연구원 생물자원센터(KCTC)와 국립농업과학원 농업미생물은행(KACC)의 미생물자원 교류와 협력을 위한 세미나가 있었습니다. 이 때에 KACC의 국균(麹菌, 누룩곰팡이) 연구에 대하여 정리하여 발표하였는데요, 이 중에서 서문에 해당하는 누룩곰팡이 소개가 일반인에게 도움이 될 것 같아 소개합니다. 인터넷 여기저기를 봐도 정확한 정보를 주는 데가 없더라고요.
그럼, 누룩곰팡이에 대한 프리젠테이션을 시작합니다.

먼저 협의의 누룩곰팡이의 의미부터 설명해야겠네요. 술은 효모가 포도당을 먹고 알코올을 배설하는 것으로 만들어집니다. 그런데 효모는 포도당만 먹을 수 있지 포도당이 사슬로 연결된 전분과 같은 큰 분자는 못 먹어요. 그런데 우리가 술을 담고자 하는 쌀은 불행히도 전분으로 되어 있어요. 따라서 누군가가 이 전분의 포도당 사슬을 끊어 낱개의 포도당으로 만들어 주어야 합니다. 이 역할을 하는 것이 누룩곰팡이지요.

술만 그런 것이 아니고 장(醬)도 비슷합니다. 콩은 40% 이상이 단백질로 구성된 단백질 덩어리예요. 그런데 콩을 구성하는 단백질들은 특별히 맛도 없고 소화도 잘 안 되는 거대 단백질들이에요. 따라서 사람들은 콩을 잘 못 먹으면 소화를 못 시켜 설사도 하고 그러지요. 그런데 곰팡이가 발효하여 이들을 펩타이드(아미노산의 소수 연결체)와 아미노산으로 잘라 놓으면 이제 감칠맛, 구수한 맛이 나는 장(醬)이 됩니다.
"이와 같이 곡물에 자라면서 전분, 단백질 분해효소 등을 생산하여 곡물을 사람에게 유효한 영양소로 바꾸어 놓는 곰팡이를 국균(麹菌)이라고 합니다. 그리고 국균을 풀어 읽으면 누룩곰팡이가 되고요."
이러한 측면에서 보면 메주의 곰팡이도 넓은 의미의 누룩곰팡이죠. 국균에 대한 의미는 한중일 삼국이 모두 다른데 오늘 저는 일본 개념의 국균(누룩곰팡이)에 대하여 설명하겠습니다. (* 한중일 삼국의 국균에 대한 자세한 설명은 각주를 참고 바랍니다.)

누룩곰팡이는 일반적으로 황국균, 흑국균, 백국균이 주이고요, 중국에서는 홍국균을 중시하고 일본에서는 가쓰오부시균을 추가하지만, 오늘은 황, 흑, 백국균에 대하여만 설명 드리도록 하겠습니다.

황국균(黄麹菌)이라 부르지만 실제 이 곰팡이를 키워보면 노란색은 아닙니다. 보시는 것처럼 배지에서는 황녹(yellow green)으로 자랍니다. 황국균의 학명은 Aspergillus oryzae인데 종명 oryzae는 벼의 학명 Oryzae sativa로부터 왔습니다. 동경대학 초빙교수로 재직 중이던 독일인 Ahlburg가 일본주(사케)를 만드는 쌀 코지로부터 이 곰팡이를 처음 분리하여 학명을 붙였기 때문입니다.
황국균은 일본의 주요 음식인 미소와 사케(일본주)를 만들뿐만이 아니라 각종 산업효소 생산 등에 사용되어 일본 내에서만 연 50조원의 경제 효과를 창출한다고 합니다. 이에 황국균은 누룩곰팡이 중에서도 일본을 대표한다는 의미로 ニホンコウジカビ(일본누룩곰팡이)로 불립니다.

흑국균은 황국균에 비하여 좀 더 빨리, 많이 자라고 무엇보다 glucoamylase 생산이 우수합니다. 아밀레이스 생산이 우수하다는 것은 쌀로부터 포도당을 더 많이 생산하고, 이는 더 많은 양의 알코올 생산으로 이어집니다. 따라서 향이나 맛보다는 알코올 량이 더 중요한 소주 생산에 이 곰팡이는 매우 유용합니다. 또한 흑국균은 구연산 등의 유기산을 생산하여 술의 pH를 낮게 유지하여 잡균의 오염을 방지합니다.
흑국균은 원래 오키나와의 소주 아와모리주를 만드는 곰팡이였습니다. 이 균이 1900년대 초에 오키나와에 인접한 큐슈우 지방으로 들어오고 점차 일본 전역으로 확대 사용되었습니다. 흑국균의 학명은 Aspergillus luchuensis 인데 종명 luchuensis는 오키나와 지역을 일컫는 류큐열도의 luchu와, 어디에서 유래하다는 뜻의 ensis의 합성어 입니다. 흑국균은 대부분 Asp. luchuensis이지만 일부 흑국 균주는 A. tubingensis와 A. niger에 속합니다.

흑국균에서 검정색 물을 뺀 것이 백국균입니다. 흑국균은 아밀라아제 생산이 우수하여 알코올도 잘 만들어 좋은데 시커먼 포자를 만들어 종균을 생산하는 회사의 건물도 시커멓고, 사람도 시커메져서 어려운 점이 있습니다.
이 때에 일본인 양조업자 Kawachi 씨가 흑국균의 백색돌연변이주를 발견하고, 이를 가지고 소주를 만들었더니 흑국균과 동일한 결과를 내었습니다. 흑국균의 문제점을 해결한 백국균은 일본을 비롯하여 한국, 대만 등에 퍼지게 됩니다. 백국균은 특히 우리나라에서 많이 사용되는데, 우리나라 막걸리는 대부분 이 백국균으로 만듭니다. 또한 우리가 전통소주라고 하는 진정한 의미의 소주(희석식 소주와 차별)도 많은 경우는 백국균으로 만드는 것으로 알고 있습니다.
백국균은 흑국균으로부터 유래하였기에 학명은 흑국균과 똑같이 Aspergillus luchuensis를 사용하지만, 차별을 위하여 돌연변이주임을 표시한 Aspergillus luchuensis mut. kawachii도 함께 사용합니다.
이상과 같이 황, 흑, 백국균을 포함하는 누룩곰팡이에 대하여 말씀드렸는데요, 일본에서는 이들의 경제, 사회, 문화적 영향력이 지대합니다. 이에 2008년에 일본양조학회가 주동이 되어 이들 누룩곰팡이(麹菌)를 국균(國菌, National fungi)으로도 지정하였습니다.
누룩곰팡이에 대한 소개를 마치기 전에 위의 국균 인정 선언문에 보면 A. sojae가 언급이 됩니다. 이에 대하여 혼란스러울 것 같아 추가 소개합니다. A. sojae는 A. oryzae와 같은 형태적인 특징을 뛰기 때문에 황국균에 포함은 됩니다. 다만 분자적으로는 명확히 구분됩니다. A. sojae는 간장 만드는데 사용이 되고, 산업적으로만 사용되고 야생균은 없습니다. 정리하면 A. sojae도 황국균이기는 하지만 일반적으로 황국균 하면 A. oryzae라고 생각하면 됩니다.
(脚註)
국균의 국에 대한 추가 설명입니다. 이 국에 대한 한중일의 글자모양과 의미가 서로 다른데, 먼저 이 국을 가장 많이 쓰는 일본은 麹자로 쓰고 コウジ (koji)로 읽습니다. 황, 흑, 백, 가쓰오부시 국균이 쌀, 콩, 보리, 가다랑어(가쓰오부시용)에 자란 것을 말합니다. 이들의 麹菌은 Aspergillus 속을 말합니다 (https://ja.wikipedia.org/wiki/%E9%BA%B9).
중국은 麴을 쓰고요(저는 曲을 주로 쓰는 것으로 알고 있는데 일단 중국판 wikipedia에는 麴으로 되어 있네요) 홍국(紅麴)을 최고로 칩니다. 중국은 Aspergillus 외에도 홍국을 만드는 Monascus, 그리고 Rhizopus, Mucor, Neurospora까지 넓은 의미로 국균을 사용합니다 (https://zh.wikipedia.org/wiki/%E9%BA%B4).
우리나라는 麴이라는 한자를 사용하고요, 누룩이라 읽습니다. 한국의 국은 일반적으로는 술을 만드는 효소제로 한정하고 있는 것 같습니다. 장(醬)을 만드는 국은 메주로 구분하여 사용합니다.
<2018.05.26., 곰박>
※ 이 글은 저자의 개인적인 판단으로 작성한 글로서 소속기관의 정책방향과는 관련이 없습니다.